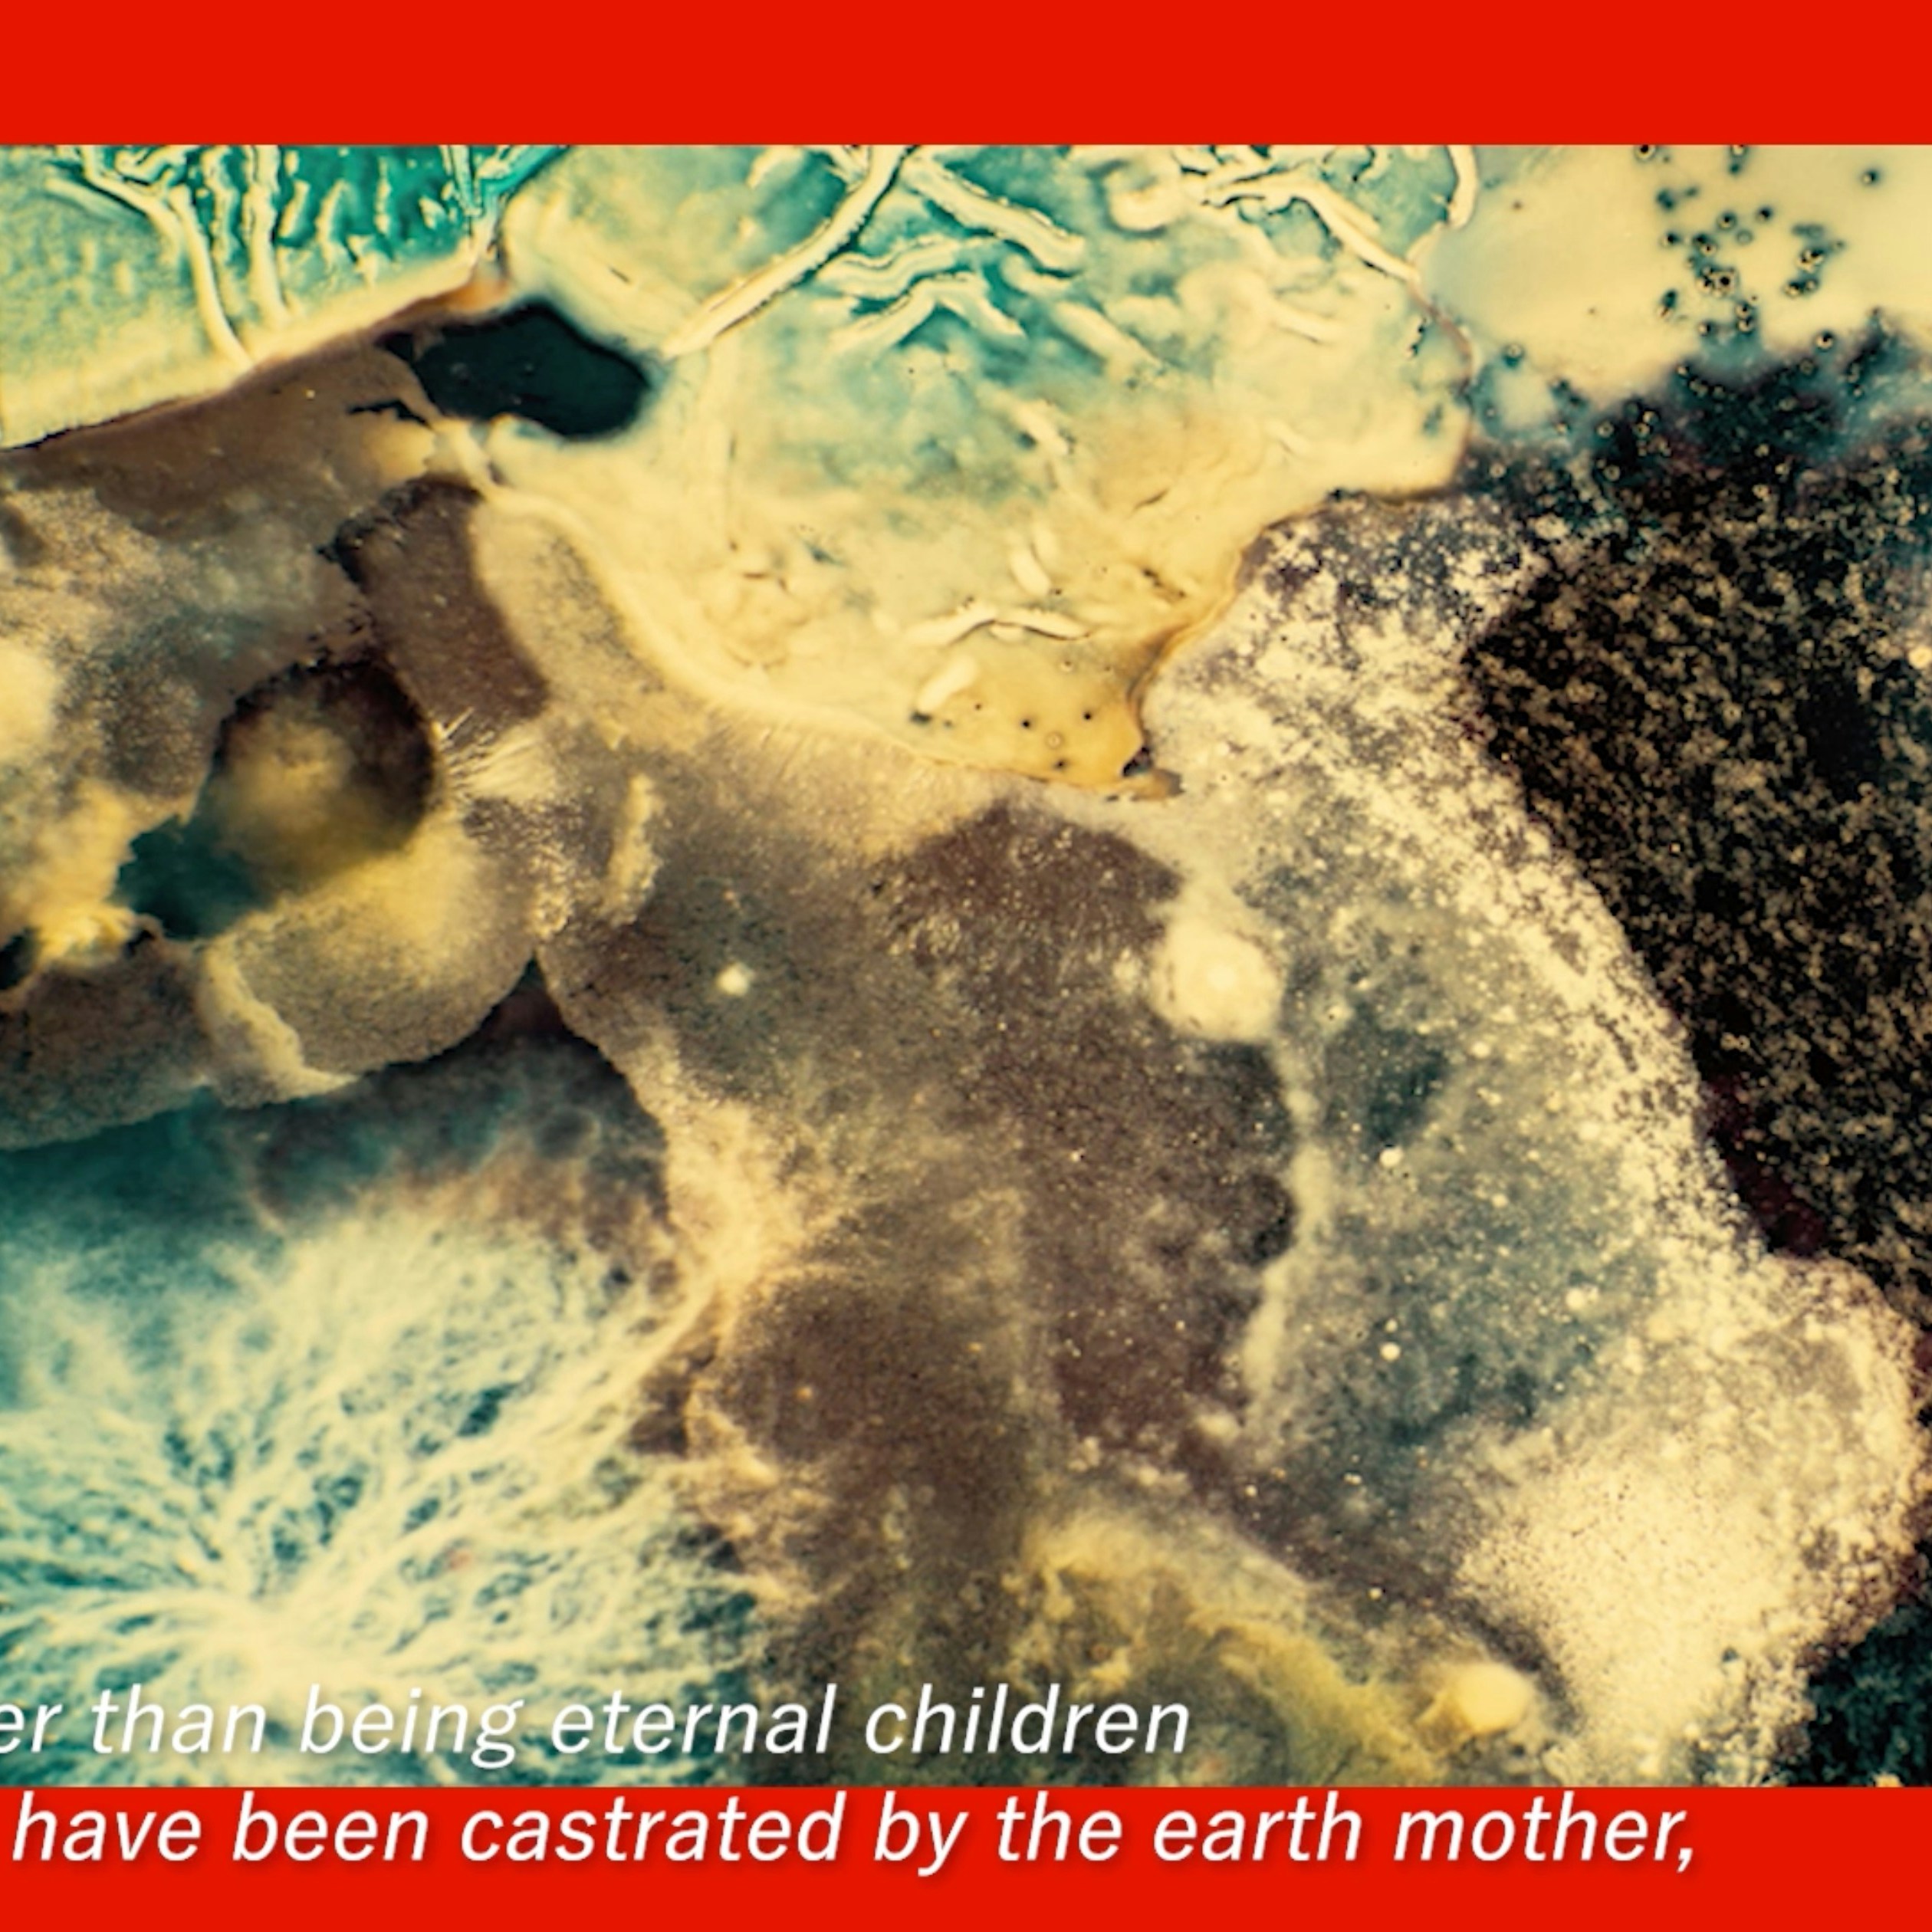

私とは、私たちとは、いったい何者なのか? 奥野克巳評。大小島真木個展「私ではなく、私ではなくもなく ”not〈 I 〉, not not〈 I 〉“」「千鹿頭 A Thousand Deer Heads」。
「絡まり、もつれ、ほころびながら、いびつに循環していく生命」をテーマに制作活動を行うアートユニット・大小島真木。秋から冬にかけて東京で開催の2つの個展「私ではなく、私ではなくもなく ”not〈 I 〉, not not〈 I 〉“」、「千鹿頭 A Thousand Deer Heads」(〜2024年1月14日)では、絵画、彫刻、映像作品の新作を発表した。2つの展示で大小島が提起する問いを人類学者の奥野克巳が考察する。

私とは、私たちとは、いったい何者なのか?
アートユニット・大小島真木の「私ではなく、私ではなくもなく ”not〈 I 〉, not not〈 I 〉“」(HARUKAITO by island)と「千鹿頭 A Thousand Deer Heads」(調布市文化会館たづくり)という2つの展覧会の深層には、「私とは、私たちとは、いったい何者か」という問いが潜んでいる。小論では、2つの展覧会において展示上映された映像作品を、そこで語られるテキストを軸に読み解いてみたい。

人間であるという「嘘」を忘れる私
HARUKAITO by islandにおいて展示された作品《Re Forming〈I〉》は、AIによる画像生成プログラムによって様々に描き出された人間と異種のキマイラ像が、「私の輪郭」をめぐる様々な考察が綴られたテキストとともに生成変化する映像作品である。
そのテキストにおいて、大小島は、大きな絵を描く時、布を床に敷き詰め、その上を這うように描くのだと語る。彼女が無心に床を這っていると、時折、同じように床の上を這っている虫と目が合う。彼女は、虫は一体「何をしているのだろう?」と思う。たぶん虫もまたも、同じことを思っているはずだと言う。そう述べる時、大小島は虫のパースペクティヴを意識している。

それは近年、存在論的人類学で取り上げられるようになった「パースペクティヴィズム」(*1)に近い感性と経験だ。Ph. デスコラ(*2)によれば、アマゾニアのアチュアル(*3)にとって、自らを人間であると思っているヘビは、私たち人間を襲ってくるが、ヘビには人間はバクに見えている。
翻って、床を這う虫が大小島を非人間と見ていると、大小島が思っているわけではない。厳密に言えば、それは「パースペクティヴィズム」ではないが、彼女は、虫のパースペクティヴから世界を見ようとしている。興味深いのは、大小島がそこから一気に、R. ウィラースレフ(*4)によって報告されたシベリアのユカギール(*5)の「パースペクティヴィズム」の核心部に踏み込んでいることである。
ユカギールのハンターは狩猟前日の夕刻から、目に見えない次元で獲物であるエルクを誘惑しにかかる。ウォッカなどの舶来品を火中に投げ入れ、エルクの支配霊を淫らな気分にさせて、夢の中で性交する。翌朝ハンターが、エルクの皮で覆われたスキーを履いてエルクのような音を出し、よたよたと揺れ動いて前進しながらエルクを模倣し始めると、性的興奮の絶頂を期待して、エルクはハンターめがけて走り寄って来る。ハンターはエルクを引きつけておいて、銃で撃ち殺す。それが、ユカギールの狩猟実践である。
ユカギールのハンターが獲物をしとめるために重要なのは、獲物を模倣して、獲物に「なる」ことである。しかし、完全に獲物になってしまったなら、獲物をしとめることができない。ウィラースレフによれば、狩猟の場面では、ハンターがエルク(「私=ではない」)ではないが、エルクでないわけでもない(「私=ではない=のでもない」)という奇妙な融合が生じている。

この記述分析を手がかりとして、大小島は、再帰的に自分自身へと立ち戻る。彼女は床の上を這っている虫と目が合った時、「私は〈私〉が人間であることを忘れる」と言う。続けて、以下のように述べる。
〈私〉が人間であるという嘘を忘れる。嘘? 〈私〉が人間であることが?
大小島にとって、人間であることは「嘘」だったのだ。虫と目が合って、人間であるという「虚構」を忘れて、私が一体何者であるのかを見つめ直すと言うのだ。
そうだとすれば、その時の〈私〉とはいったい何者だというのだろう? 〈私〉は虫だろうか。〈私〉は絵筆だろうか。〈私〉は顔料だろうか。〈私〉は床だろうか。おそらく、〈私〉はそのいずれでもない。そしてまた、そのいずれでもなくもない。
その時、私は虫であるのだろうか。あるいは絵筆や顔料や床でもあるのかもしれない。いや、そのいずれでもないのかもしれないし、そのいずれでもなくもない。私とは、そうした高速交換する揺らぎの只中に移ろう無常の存在なのかもしれない。
「まなかい」の世界の私
ところで大小島は、虫と目が合うというようなことだけでなく、動物や植物、地形や現象からまなざされているのを感じる時があると言う。人間は、非人間や人間以上の事象などの無数のまなざしが交差する「あいだ」を生きてきたのだ。大小島は、この点を踏まえて、以下のように述べる。
まなざしが交わることを「まなかい」という。日本では性交渉の意味も持つこの言葉は、そのまま無数のまなざしが交差するこの世界のあり様を表しているように思う。「まなかい」としての世界――そう言えば、私は作品を制作する時、誰のまなざしを意識しているのだろう。あるいはそもそも、芸術作品とは誰のまなざしに向けてつくられてきたものなのだろう。
まなざしだけでなく、体もまた交わることを含む「まなかい」の世界。私たちが、「まなかい」を生きているのだとすれば、私や、私たちは、諸存在や諸現象との交渉、「いうなれば、『まなかい』としての世界における外交」をつうじて世界に現れうるのだと言えよう。
私たちを〈私たち〉たらしめている文化とは総じて、私たちの内側から自発的に生まれてきたものではなかったはずだ。
私たちの文化は、内側からでなく、外側のまなざしによって生み出されたのである。
正装したユカギールのハンターは、美しい装飾品を身につける。色とりどりの紐やビーズ細工で精巧に飾られた弾薬帯や、金属細工で美しく飾られた鞘付きナイフなどである。ユカギールによれば、そうした美しい装飾品に魅入られて、動物はハンターに身を捧げるのである。
そうだとすれば、人が身につける装飾品とは、もともとは動物のまなざしを惹きつけるためのものだったのではないか。大小島によれば、「〈私たち〉はみな相互に、それぞれがそのようであるところの理由を、〈私たち〉でないものたちのまなざしに負っている」。
〈私たち〉をつくりだしているのが、〈私たち〉ではないものたちのまなざしであり、逆もまたそうであるのだとすれば、それを〈私たち〉と呼ぶことに、一体、どのような意味があるというのだろうか。
私たちが、私たちでない他者のまなざしによってつくられ、他者もまた私たちのまなざしによってつくられているのだとすれば、私たちとは、一体誰のことなのか。私や、私たちとは、その都度つくられる輪郭に与えられた名前にすぎないのではないのか。私という実体などどこにも存在しないのだ。
だから大小島は、「〈私〉ではなく、〈私〉でなくもないもの」としての私を、繰り返し、何度でも描き直す。
「根源的不能性」と私たち
T. インゴルド(*6)は、「飛行について」と題するエッセイ(『応答、しつづけよ。』(奥野克巳訳、亜紀書房、2023)所収)で、飛行機や船の機械的な原理に触れている。飛行機は、プロペラやジェットエンジンで空の中を掘るように進む。船は、あたかもそれが通過する道に穴を作るかのように、プロペラで海洋を穿ちながら進む。飛行機も船も動力源を用いて、空気や水を上回る乱流を生み出しながら前進する。飛行機には空気が、船には水が、媒体であると同時に克服すべき抵抗である。
それに対して、空を飛ぶ鳥や水を泳ぐ魚は、根本的に、飛行機や船とは動作原理が異なる。鳥や魚の体は、それぞれヒレと翼を備え、媒体に逆らうのではなく、媒体とともに動く。鳥にとっての空気や、魚にとっての水は、穴を穿たなければなければならない物質の塊ではない。それらは、上昇温暖気流や渦巻きを生み出すべく動いている物質が織りなす質感である。
インゴルドによれば、鳥は、機械的ではなく、実存的な原理に従って飛ぶ。鳥は空を飛ぶ時、「空に=属する=一羽の鳥」になる。だが人間は「空=に属する=一人の人間」にはなれない。人間は機械の助けがなければ飛ぶことができないからである。
しかし夢の中なら、人間も空を飛ぶことができる。夢の中で、人は空へと飛ばされ、運ばれていく。また現実でも、強風の中を歩いていると、人間はまるで飛んでいるかのように感じることがある。
そう考えれば、夢の中と現実の両方で、人間は飛ぶことができるのではないか。私たちは、歩くことを、二本足で飛んでいるとみなすべきではないだろうか。インゴルドによれば、人間は助けがないと飛べないのではなく、実際には風の中を飛ぶ存在なのである。
一般に、空気を上回る乱流を生み出しつつ抵抗を克服して機械的に飛ぶのが人間である。しかし人間の中にも、機械の力で飛ぼうとするのではなく、自然の力に逆らうことなく、それをただ受け流す人たちがいる。彼らは、夢の中で飛び、強風に吹かれて飛ぶこと以外に、自らの動力を生み出し、その力で実際に飛んでみようとは思いもしなかったのである。
日本列島の住民はそういう人たちであった。大小島が長野県諏訪地方に滞在し、その地の歴史、風土、民俗から触発されて制作したという作品群を一堂に集めた「千鹿頭」展のエントランス間際に展示された映像インスタレーション《根源的不能性 Radical Impotency》の5つのモニターでは、日本列島の民がいかにして「根源的不能性」を得るようになったのかの経緯が示されている。「根源的不能性」とは、自然に抗して人間の主体的な力を行使することが無駄なことだと観念することである。

日本列島は原初の時代、真二つに裂けていた。やがて海底火山の噴火で、海面から盛り上がった地形が裂け目を埋めていった。列島はその後、激しく揺れ、火を噴き上げ、多くの生命の死をもたらした。裂け目とは、あらゆる生の起源であり、また同時に死の起源でもある。大地がもたらす生と死の両義性を、列島の民は早くから知っていた。
疼き続ける大地で生き抜く過程で、日本列島の人々の精神性は形づくられてきた。地震、噴火、天変地異という自然の猛威に対して抱くようになった自分たちの不能感、つまり「何もしえなさ」に由来する精神性が、そこでは養われたのである。繰り返し襲いかかる自然の圧倒的な力を前にして、それとは別の力によってその制御を試みることは、列島に住まう人々にとって不可能であったばかりか、無意味なことでさえあった。
大小島は、日本ではあらゆる問題が、その原因の深い追求がなされることのないまま、あいまいなままに緩やかに流されていくと指摘する。それは、はたして無責任で幼稚な態度なのだろうか?
いやそれは、何もなしえない者たちが、「根源的不能性」によって生きていくために身につけた「知恵」だったのではないか。私たち日本列島の民は、自然に抗うのではなく、それをいなしてきた。その意味で、私たち日本列島の民は、夢の中で鳥のように空を飛び、また二本足で強風の中を飛ぶ、実存的な鳥=人間のような存在なのである。
ところで、同展の中で展示上映されたもうひとつの映像作品《千鹿頭》は、エピグラフを除いて言葉は一切使われていない。それは、出演者の身体動作によって生み出された創作神話のような作品である。彼らは、生と死が交差する森で、出たり入ったり誘ったり誘われたりを繰り返す。出演者たちの逞しくも不能感に満ちた佇まいが、一面の緑と赤の残像がいつまでも脳裏に明滅し続ける鮮やかな映像とともに、観る者の心に深く刻みつけられる。

*1──動物や精霊などの非人間が、自らを人間と見る一方で、人間のことを非人間と見る、アメリインディアン諸社会に見られる世界理解のこと。
*2──フランスの人類学者(1949〜)。邦訳書に、『自然と文化を越えて』(小林徹訳、水声社、2020)。
*3──エクアドルとペルーの国境地帯に住む先住民。
*4──デンマークの人類学者(1971〜)。
*5──ロシア・サハ共和国コリマ川上流域に住む先住民。
*6──イギリスの人類学者(1948〜)。邦訳書に、『ラインズ 線の文化史』(工藤晋訳、左右社 、2014)、『メイキング 人類学・考古学・芸術・建築』(金子遊・水野友美子・小林耕二訳、左右社 、2017)、『生きていること 動く、知る、記述する』(柴田崇・野中哲士・佐古仁志・原島大輔・青山慶・柳澤田実訳、左右社 、2021)、『人類学とは何か』(奥野克巳・宮崎幸子訳、亜紀書房、2020)など。